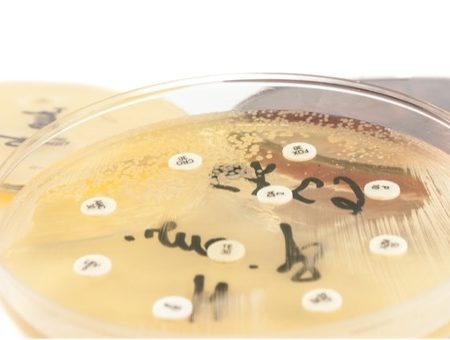
Antiobiotico resistenza: il cattivo uso del farmaco

Lo stress: da meccanismo fisiologico a squilibrio pericoloso, da eustress a distress Parliamo di stress e per non tralasciare nulla […]


Sindrome da colon irritabile: alimentazione e stile di vita
Alimentazione, esercizio fisico, riposo e fattori psicologici: cambiare stile di vita per curare una sindrome che interessa fino al 18% […]


Disturbi neurocognitivi e dell’umore: tutto parte dall’intestino?
L’asse intestino – cervello nel caso dei disturbi neurocognitivi Gli studi dimostrano ormai da lungo tempo una correlazione importante fra […]


Metabolismo del triptofano e neurotossici
Dall’ansia alla depressione ai processi neuroinfiammatori torniamo sul ruolo delle molecole del benessere con il metabolismo del triptofano Abbiamo già […]


Serotonina e triptofano le molecole del benessere indispensabili alla salute mentale
Ansia depressione insonnia e mal di testa possono dipendere da una carenza di serotonina e triptofano L’impatto dell’alimentazione sulla salute […]


Allergia al polline e ipersensibilità agli alimenti
Se la primavera fra allergia al polline e sensibilità agli alimenti ipersollecita il nostro sistema immunitario Continuiamo a parlare di […]


Depurazione dell’organismo in primavera: forti e in salute
Il ruolo centrale dell’alimentazione e il test delle intolleranze alimentari per spegnere e prevenire gli stati infiammatori Siamo entrati nella […]


Malattie infiammatorie croniche intestinali in primavera
Il contraccolpo sui pazienti affetti da MICI del fattore stagionale, i controlli l’alimentazione e lo stile di vita alleati essenziali […]


Fibromialgia: ne soffrono circa 2 milioni di Italiani
L’Osservatorio Malattie Rare mette in guardia sui numeri in crescita della sindrome fibromialgica una patologia ancora non risconosciuta a livello […]

Antiobiotico resistenza: il cattivo uso del farmaco
Che cos’è l’antibiotico resistenza e perché deve farci riflettere L’antibiotico resistenza è un fenomeno biologico che si verifica quando alcuni […]
